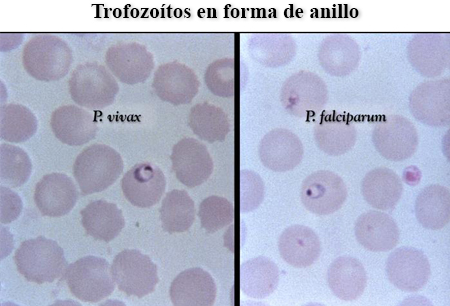
Malaria images

Resumen
Definición
Anamnesis y examen
Principales factores de diagnóstico
- presencia de factores de riesgo para contraer la malaria
- presencia de factores de riesgo de enfermedad grave
- Fiebre o antecedentes de fiebre
Otros factores de diagnóstico
- cefalea
- debilidad
- mialgia
- artralgia
- anorexia
- diarrea
- convulsiones
- náuseas y vómitos
- dolor abdominal
- palidez
- hepatoesplenomegalia
- ictericia
- nivel de alteración de la consciencia
- hipotensión
- sangrado
- anuria/oliguria
- taquipnea
Factores de riesgo
- viaje a zona endémica
- quimioprofilaxis inadecuada o no realizada
- ausencia de mosquiteros tratados con insecticidas en las zonas endémicas
- baja inmunidad del huésped (enfermedad grave)
- embarazo (enfermedad grave)
- edad <5 años (enfermedad grave)
- Compromiso inmunológico (enfermedad grave)
- edad avanzada (enfermedad grave)
- desnutrición (enfermedad grave)
- administración de hierro (niños)
Pruebas diagnósticas
Primeras pruebas diagnósticas para solicitar
- frotis de gota fina y gruesa preparados con tinción de Giemsa
- pruebas diagnósticas rápidas (PDR)
- hemograma completo (HC)
- perfil de coagulación
- urea, creatinina y electrolitos séricos
- pruebas de función hepática (PFH) séricas
- glucosa sérica
- análisis de orina
- gasometría arterial
Pruebas diagnósticas que deben considerarse
- reacción en cadena de la polimerasa (PCR) en sangre para malaria
- radiografía de tórax
- hemocultivo
- urocultivo
- cultivo de esputo
- punción lumbar
- prueba del VIH
- Hisopados nasofaríngeos por PCR para gripe o COVID-19
- TC craneal
Pruebas emergentes
- amplificación isotérmica mediada por bucles
Algoritmo de tratamiento
enfermedad grave (o incapacidad para tomar medicación oral inicialmente): todas las especies de Plasmodium
Plasmodium falciparum (o especie desconocida): enfermedad sin complicaciones
Plasmodium ovale: enfermedad sin complicaciones
Plasmodium vivax: enfermedad sin complicaciones
Plasmodium malariae o Plasmodium knowlesi: enfermedad sin complicaciones
Plasmodium falciparum: infección recurrente
Colaboradores
Autores
Elizabeth Ashley, MB BS, FRCP, FRCPath
Director
Institution Lao-Oxford-Mahosot Hospital - Wellcome Trust Research Unit
Vientiane
Laos
Honorary Consultant in Infectious Diseases and Microbiology
Oxford University Hospitals NHS Foundation Trust
Professor of Tropical Medicine
University of Oxford
Oxford
UK
Divulgaciones
EA is an associate editor of Malaria Journal, an academic editor for PLOS Medicine, and is on the Lancet Infectious Diseases International Advisory Board. EA is on the council of the International Society for Infectious Diseases. The Institution Lao-Oxford-Mahosot Hospital - Wellcome Trust Research Unit receives core funding from the Wellcome Trust. EA is an author of a number of references cited in this topic.
Arjun Chandna, BA MRCP AFHEA
Clinical Research Fellow
Centre for Tropical Medicine and Global Health
University of Oxford
Oxford
Specialty Registrar in Infectious Diseases and Medical Microbiology
University College London Hospitals NHS Trust
London
UK
Divulgaciones
None.
Agradecimientos
Dr Elizabeth Ashley and Dr Arjun Chandna would like to gratefully acknowledge Professor Ron Behrens, Mariyam Mirfenderesky, Dr Signe Maj Sorensen, Dr Joanna Allen, Dr Simon Warren, and Dr Behzad Nadjm, previous contributors to this topic.
Divulgaciones
RB acted as a paid expert to the courts on malaria prophylaxis. RB received fees on the Travel Health advisory board for Emergent BioSolutions. RB prepared education material for the Royal College of Physicians and Surgeons of Glasgow. RB is an author of a number of references cited in this topic. MM, SMS, JA, and SW declare that they have no competing interests. BN is an author of a reference cited in this topic.
Revisores por pares
Blaise Genton, MD
Professor
Head of the Travel Clinic
Consultant of Tropical and Travel Medicine
University Hospital
Project Leader
Swiss Tropical and Public Health Institute
Basel
Switzerland
Divulgaciones
BG has received a research grant from Novartis Pharma to assess the impact of the introduction of artemether-lumefantrine (Novartis) as first-line treatment for uncomplicated malaria on mortality of children under 5 years old in 2 districts in Tanzania and travel grants from Novartis Pharma to present the results of the study above. BG is an author of a reference cited in this topic.
David Sullivan, MD
Associate Professor
Malaria Research Institute and Department of Molecular Microbiology and Immunology
Johns Hopkins Bloomberg School of Public Health
Baltimore
MD
Divulgaciones
DS has received royalties from antigen provision for a diagnostic test to Inverness. DS with Johns Hopkins University has patents on diagnostic tests that do not require blood.
Walther H. Wernsdorfer, MD
Professor
Institute of Specific Prophylaxis and Tropical Medicine
Medical University of Vienna
Vienna
Austria
Divulgaciones
WHW declares that he has no competing interests.
Agradecimiento de los revisores por pares
Los temas de BMJ Best Practice se actualizan de forma continua de acuerdo con los desarrollos en la evidencia y en las guías. Los revisores por pares listados aquí han revisado el contenido al menos una vez durante la historia del tema.
Divulgaciones
Las afiliaciones y divulgaciones de los revisores por pares se refieren al momento de la revisión.
Referencias
Artículos principales
World Health Organization. WHO guidelines for malaria. Nov 2024 [internet publication].Texto completo
Centers for Disease Control and Prevention. Clinical guidance: malaria diagnosis & treatment in the U.S. Jun 2024 [internet publication].Texto completo
Artículos de referencia
Una lista completa de las fuentes a las que se hace referencia en este tema está disponible para los usuarios con acceso a todo BMJ Best Practice.
Diferenciales
- Dengue
- Infección por el virus Zika
- virus Chikungunya
Más DiferencialesGuías de práctica clínica
- Management of treatment failure (recrudescence) in falciparum malaria
- Malaria diagnosis and treatment in the US
Más Guías de práctica clínicaFolletos para el paciente
Prevención de la malaria
Más Folletos para el pacienteVideos
Punción lumbar diagnóstica en adultos: demostración animada
Más vídeosInicie sesión o suscríbase para acceder a todo el BMJ Best Practice
El uso de este contenido está sujeto a nuestra cláusula de exención de responsabilidad
